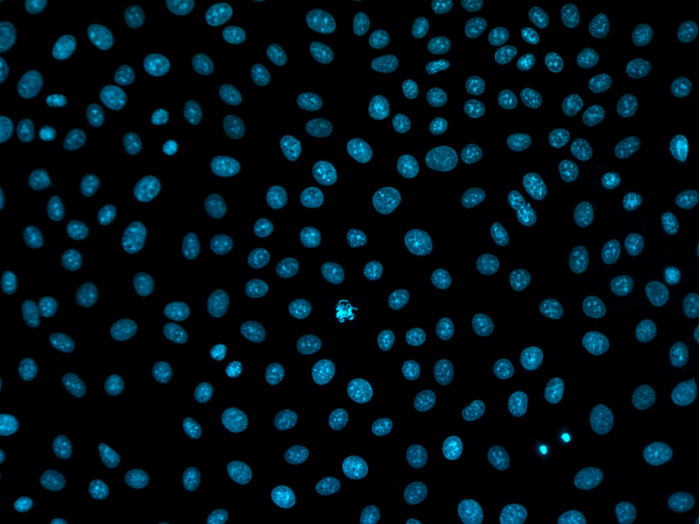
产品细节图片6

相关产品推荐更多 >
万千商家帮你免费找货
0 人在求购买到急需产品
- 详细信息
- 询价记录
- 文献和实验
- 技术资料
- 库存:
99
- 供应商:
ibidi

DAPI在染色和安装在一个单一步骤
使用于宽场荧光和共聚焦显微镜在免疫荧光分析中的应用
滴管瓶用于将精确分配到管道或开放孔中
明亮的荧光信号,背景荧光较低
型号:50011
应用:
免疫荧光使用核DAPI复染的测定
宽场荧光和共聚焦显微镜
染色玻片和培养皿的短期与长期储存
技术特点:
特别设计用于安装µ-Slides, µ-Dishes, and µ-Plates。
包含用于核反染的DAPI,也可以在没有DAPI的情况下用
含有抗氧化剂(DABCO)能保存荧光色素
为检测荧光信号提供最佳pH值
不干燥、不硬化、体积稳定
较低背景的低自发荧光

带DAPI的ibidi封片介质原理
含DAPI的水性非硬化ibidi封片剂是贴装需要对细胞核复染的免疫荧光染色样品的理想选择。
它专门设计用于ibidi μ-Slides和μ-Dishes。由于非硬化,带有DAPI的ibidi封片剂也有助于将样品安装在channel μ-Slides中。
含有DAPI的ibidi封片剂含有工作浓度的DAPI(4',6-二脒基-2-苯基吲哚),这是一种方便的DNA结合荧光染料。该细胞核标记是一种强大的核/染色体复染剂,是免疫荧光测定的金标准。
当与DNA结合时,DAPI的荧光强度远高于其在溶液中时的荧光强度。这样就可以进行直接荧光显微镜检查,并长期存储使用带有DAPI的ibidi封片剂安装的载玻片。
DAPI荧光信号的最大激发波长为358 nm,发射最大值为461 nm,与免疫细胞化学中其他常用荧光染料(例如,GFP和具有更长波长的类似染料)表现出最小的光谱重叠。

使用带有DAPI的ibidi封片剂安装后HeLa细胞的延时视频。加入封片剂后,细胞被固定、透化和成像。

安装介质的滴管瓶与DAPI更方便地填充各种腔室,通道载玻片和培养皿

风险提示:丁香通仅作为第三方平台,为商家信息发布提供平台空间。用户咨询产品时请注意保护个人信息及财产安全,合理判断,谨慎选购商品,商家和用户对交易行为负责。对于医疗器械类产品,请先查证核实企业经营资质和医疗器械产品注册证情况。
- 作者
- 内容
- 询问日期
文献和实验DAPI Counterstaining Protocols
5 minutes. iv. Rinse the sample several times in PBS. Drain excess buffer from the coverslip and mount. We recommend using a mounting medium with an antifade reagent such as our SlowFade® Gold antifade reagent or ProLong® Gold
, making certain that the cells are completely covered. C. Incubate for 1–5 minutes. D. Rinse the sample several times in PBS. Drain excess buffer from the coverslip and mount. We recommend using a mounting medium with an antifade
Anti-GFP/BrdU In Situ Immunostaining
IgG (Jackson ImmunoResearch, 111-096-006) Biotinylated anti-BrdU (AbCam, ab2284-125) Streptavidin-Alexa Flour 555 (Invitrogen/Molecular Probes, S21381) Goat serum Horse serum BSA 2N HCl DAPI Fluorescent mounting medium (Vectashield
技术资料暂无技术资料 索取技术资料











